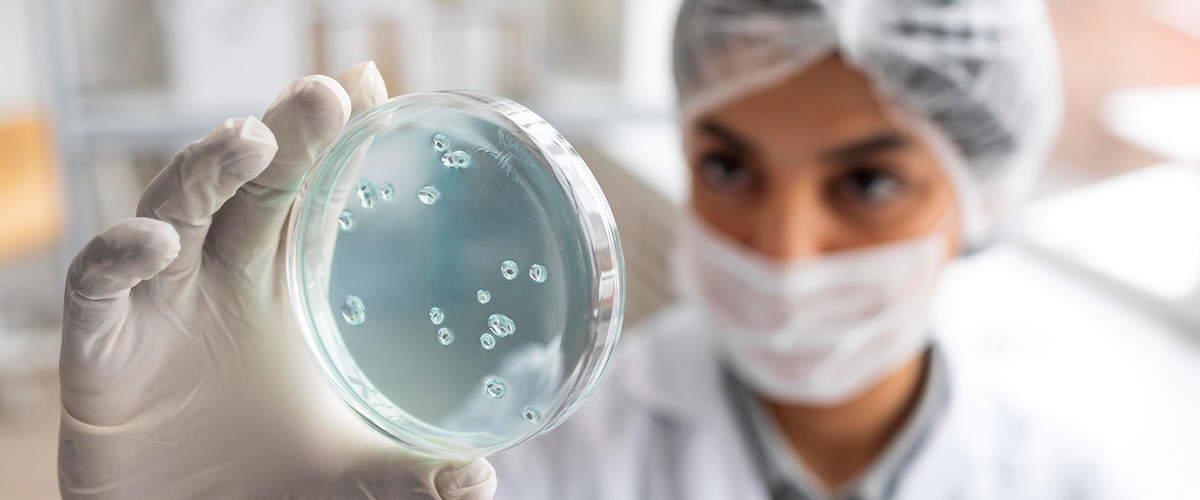
hero image

Salute Umana
Una grande rete con università e istituti di ricerca in tutto il mondo ha permesso a Turval di concentrare i nostri sforzi scientifici e costruire una solida ricerca scientifica sull'uso del Lievito Lattico Probiotico, Kluyveromyces marxianus fragilis B0399 (TURVAL B0399) in quattro aree chiave della salute: salute intestinale, orale, femminile e immunitaria.
Salute Intestinale
Lo stile di vita "moderno" ci obbliga a trovare il giusto aiuto naturale per contrastare le sue conseguenze negative sul nostro equilibrio microbico, sulla salute digestiva, sulla salute immunitaria e sull'umore. In molteplici ricerche e studi clinici, Turval B0399 riduce il disagio intestinale indotto dallo stile di vita se consumato quotidianamente. Gli studi clinici, descritti di seguito, dimostrano che può alleviare i sintomi simili all'IBS (diarrea occasionale, stitichezza e gonfiore) migliorando la qualità della vita e il benessere generale. Inoltre, la particolare attività enzimatica di questo lievito aiuta la digestione di carboidrati complessi come lattosio e pectine e può prevenire i problemi digestivi associati.
MoreSalute Immunitaria
Oltre il 70% del sistema immunitario del corpo si trova nell'intestino. Quando Turval B0399 viene consumato quotidianamente, stabilizza l'equilibrio intestinale a favore di un intestino sano, supportando la funzione immunitaria attraverso l'interazione con specifiche cellule immunitarie e il microbiota intestinale.
MoreSalute della Donna
La genetica femminile combinata con lo stile di vita e i cambiamenti ormonali durante tutta la vita influenzano spesso l'immunità, l'umore, la salute digestiva delle donne, ecc. Uno dei problemi comuni è l'insufficiente difesa naturale contro la Candida albicans. Studi e sperimentazioni hanno dimostrato che, se consumato quotidianamente, Turval B0399 agisce come un guardiano contro questo patobionte, sia attraverso l'inibizione diretta che la difesa indiretta (la regolazione della risposta immunitaria e il bilanciamento della microflora endogena).
MoreSalute Orale
Le sfide della salute orale come l'alito cattivo (alitosi) e la carie sono spesso combinate con una mancanza di sufficiente igiene orale, certe scelte dietetiche e di stile di vita e colpiscono miliardi di persone in tutto il mondo, avendo un impatto negativo sulla loro qualità della vita e sulla loro salute generale. Se consumato quotidianamente, Turval B0399 bilancia la microflora dell'intestino e del cavo orale e appare come una rilevante soluzione naturale, "senza sostanze chimiche", per affrontare le condizioni di salute orale.
MoreNuove Aree della Salute
Aspiriamo a innovare le industrie guidati dalle esigenze dei nostri clienti in tutto il mondo
che sono in costante cambiamento. Cerchiamo di soddisfare questa necessità di flessibilità
attraverso continui investimenti in ricerca e creazione di nuove soluzioni.
Direzioni Future della Ricerca:
- Valutazione dell'attività degli enzimi peptidasi in riferimento all'intolleranza al glutine (celiachia).
- Somministrazione a pazienti sottoposti a chemioterapia e radioterapia (in corso).
- Identificazione del profilo enzimatico e proteomico per sviluppare nuove applicazioni.
- Diversi aspetti dell'effetto immunomodulatorio (es. patologie nutrizionali, respiratorie e dermatologiche).
- Valutazione dell'efficacia sulle patologie intestinali, in particolare diverticolite, morbo di Crohn, le IBD (malattie infiammatorie croniche dell'intestino).
- Estensione dell'efficacia nell'intolleranza al lattosio.